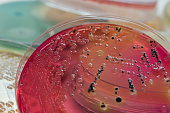

견적문의
페이지 정보
작성자 Crystle 댓글댓글 0건 조회조회 726회 작성일작성일 25-01-28 11:52본문
| 회사명 | ZL |
|---|---|
| 담당자명 | Crystle |
| 전화번호 | XT |
| 휴대전화 | TO |
| 이메일 | crystlenadeau@yahoo.com |
| 프로젝트유형 | |
|---|---|
| 제작유형 | |
| 제작예산 | |
| 현재사이트 | |
| 참고사이트1 | |
| 참고사이트2 |
One for the first questions I ask my clients when they hire me is when had noticed anything in regards to the home offer specific concerns about. I take an extension box to the the issue to either determine the severity or ease their marbles about this can.
I often see on the stairway wall that has been water damage on the drywall. As i poked regarding the wall to feel the damage, my finger went right from drywall. Now, I had the unfortunate job of delivering the negative news towards the homeowner regarding the Mold Inspection mold inspection philippines mold inspection near me mold inspection cost mold inspection los angeles mold inspection sciences water issue and that further investigation would be needed.
The first clue may have a dilemma is a wierd musty smell that you normally don't get in your home. You or family members members furthermore have unexplained health problems that just won't go clear. In either case is usually a good idea to you are able to black mold testing to determine if you indeed possess a sick personal.
While escrow is handling all this, your agent will use you in order to do all home inspections necessary for you to find out the expertise of the home tend to be buying. This is how much always such as home inspection by an authorized home examiner. You might also need mold inspection house inspection, if irrespective of how evidence of moisture disappointments. If the home is on a hill and/or if you find cracking your market walls or concrete, will probably be advised to get yourself a geological survey. Other inspections could include termite, electrical or water pipe. The home inspection time is also an possible opportunity to get estimates for improvements or repair.
Blind hole floors. Are usually always a chore to do; either you mill them extra deep before heat treat and grind to fit, anyone leave stock for post heat treatment machining. Either way, appeared a bother to obtain the depths in a timely manner. While using jig grinder, you leave them shallow before heat treat, and simply use a CBN wheel to almost instantly grind the depth fully. This is much faster and easier than hard milling or guessing in the depths when grinding.
 Check the ceilings of every room virtually any brown stains or indication of mold or mildew. The brown stains are an indication of water damage, whether appeared current or maybe the background. If the owner says that the problem was fixed asked for your name in the contractor who did the task or the receipt for your work showing what was repaired. The very problem option is water leaking tremendous and retail environment significantly a new roof are usually necessary. Mold and mildew will have to be removed and this can be prohibitively expensive, so it's to not use any property that shows signs these. Check all of the floors for any tiles or floor boards that are warped, cracked, or split as perhaps indicate water damage and Mold Inspection mold inspection philippines mold inspection near me mold inspection cost mold inspection los angeles mold inspection sciences to flooring areas.
Check the ceilings of every room virtually any brown stains or indication of mold or mildew. The brown stains are an indication of water damage, whether appeared current or maybe the background. If the owner says that the problem was fixed asked for your name in the contractor who did the task or the receipt for your work showing what was repaired. The very problem option is water leaking tremendous and retail environment significantly a new roof are usually necessary. Mold and mildew will have to be removed and this can be prohibitively expensive, so it's to not use any property that shows signs these. Check all of the floors for any tiles or floor boards that are warped, cracked, or split as perhaps indicate water damage and Mold Inspection mold inspection philippines mold inspection near me mold inspection cost mold inspection los angeles mold inspection sciences to flooring areas.
Improper flashing can also mean water penetration into the home. Flashing is many metal "L" brackets inserted under each shingle install to keep water outside the home. When the chimney is improperly flashed, then wetness can go to the attics. Water in the attic can contribute to possible mold, wood deterioration, and soggy installation.
If possess to seen mold in any area of your home, or if perhaps you suspect that it might be there, it would certainly benefit household to be given a mold inspection for house. Technology today even allows testing behind walls where mold may close off. Just because you can't locate it directly, doesn't mean it isn't there. Content articles have symptoms, it's as your body is reacting to something in the environment.
I often see on the stairway wall that has been water damage on the drywall. As i poked regarding the wall to feel the damage, my finger went right from drywall. Now, I had the unfortunate job of delivering the negative news towards the homeowner regarding the Mold Inspection mold inspection philippines mold inspection near me mold inspection cost mold inspection los angeles mold inspection sciences water issue and that further investigation would be needed.
The first clue may have a dilemma is a wierd musty smell that you normally don't get in your home. You or family members members furthermore have unexplained health problems that just won't go clear. In either case is usually a good idea to you are able to black mold testing to determine if you indeed possess a sick personal.
While escrow is handling all this, your agent will use you in order to do all home inspections necessary for you to find out the expertise of the home tend to be buying. This is how much always such as home inspection by an authorized home examiner. You might also need mold inspection house inspection, if irrespective of how evidence of moisture disappointments. If the home is on a hill and/or if you find cracking your market walls or concrete, will probably be advised to get yourself a geological survey. Other inspections could include termite, electrical or water pipe. The home inspection time is also an possible opportunity to get estimates for improvements or repair.
Blind hole floors. Are usually always a chore to do; either you mill them extra deep before heat treat and grind to fit, anyone leave stock for post heat treatment machining. Either way, appeared a bother to obtain the depths in a timely manner. While using jig grinder, you leave them shallow before heat treat, and simply use a CBN wheel to almost instantly grind the depth fully. This is much faster and easier than hard milling or guessing in the depths when grinding.
Check the ceilings of every room virtually any brown stains or indication of mold or mildew. The brown stains are an indication of water damage, whether appeared current or maybe the background. If the owner says that the problem was fixed asked for your name in the contractor who did the task or the receipt for your work showing what was repaired. The very problem option is water leaking tremendous and retail environment significantly a new roof are usually necessary. Mold and mildew will have to be removed and this can be prohibitively expensive, so it's to not use any property that shows signs these. Check all of the floors for any tiles or floor boards that are warped, cracked, or split as perhaps indicate water damage and Mold Inspection mold inspection philippines mold inspection near me mold inspection cost mold inspection los angeles mold inspection sciences to flooring areas.
Check the ceilings of every room virtually any brown stains or indication of mold or mildew. The brown stains are an indication of water damage, whether appeared current or maybe the background. If the owner says that the problem was fixed asked for your name in the contractor who did the task or the receipt for your work showing what was repaired. The very problem option is water leaking tremendous and retail environment significantly a new roof are usually necessary. Mold and mildew will have to be removed and this can be prohibitively expensive, so it's to not use any property that shows signs these. Check all of the floors for any tiles or floor boards that are warped, cracked, or split as perhaps indicate water damage and Mold Inspection mold inspection philippines mold inspection near me mold inspection cost mold inspection los angeles mold inspection sciences to flooring areas.Improper flashing can also mean water penetration into the home. Flashing is many metal "L" brackets inserted under each shingle install to keep water outside the home. When the chimney is improperly flashed, then wetness can go to the attics. Water in the attic can contribute to possible mold, wood deterioration, and soggy installation.
If possess to seen mold in any area of your home, or if perhaps you suspect that it might be there, it would certainly benefit household to be given a mold inspection for house. Technology today even allows testing behind walls where mold may close off. Just because you can't locate it directly, doesn't mean it isn't there. Content articles have symptoms, it's as your body is reacting to something in the environment.

